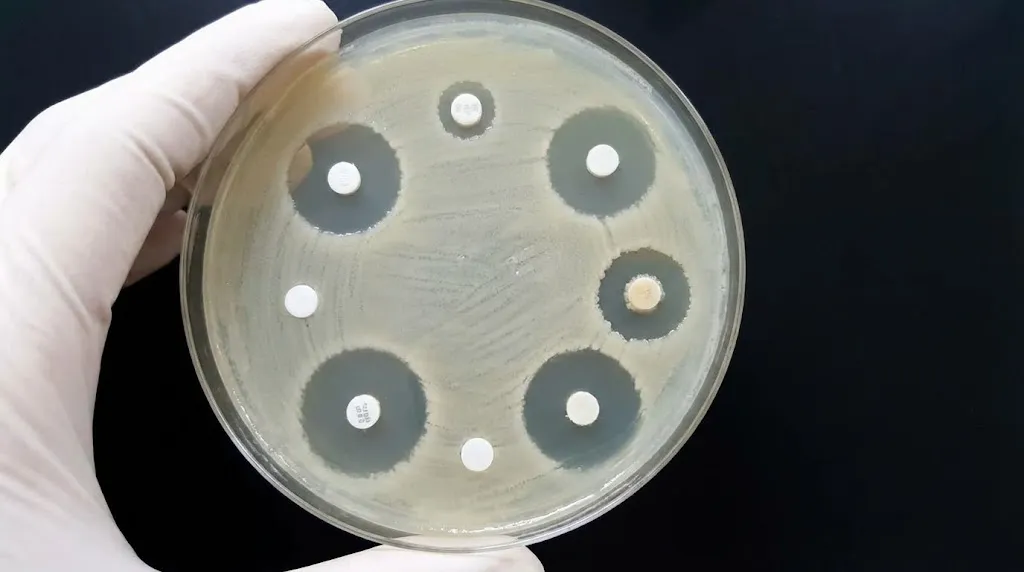

مصرف بی رویه آنتی بیوتیک عوارض زیادی را از خود در بدن به جای میگذارد که در ادامه به آن میپردازیم.
1. افزایش موارد اسهال کشنده در کودکان
از آنجایی که اکثر سرماخوردگی های رایج، ویروسی هستند، استفاده از آنتی بیوتیک هیچ تاثیری در متوقف کردن عفونت ندارد و می تواند اثرات جانبی بسیاری را درست کند. تحقیقات نشان داده است که بیش از نیمی از آنتی بیوتیک هایی که برای کودکان تجویز می شود برای عفونت بخش فوقانی دستگاه تنفسی است که سرماخوردگی رایج هم با آن همراه است. تحقیقات جدید نشان می دهد که کودکانی که برای سرماخوردگی داروی عفونت ریه استفاده کرده اند، بیشتر از دیگران در معرض ابتلا به باکتری های مقاوم به آنتی بیوتیک(سی دیف) هستند. این تحقیق نشان داد که 71درصد کودکانی که از ابتلا به سی دیف رنج برده اند چیزی در حدود 12 هفته قبل از آن، از آنتی بیوتیک های عفونت ریه برای درمان سرماخوردگی و آبریزش بینی استفاده کرده اند. در این بین، یک باکتری سی دیف نیز در روده انسان کشف شده که می تواند موجب اسهال شود و علت 250.000 مورد ابتلا در بین بیماران بستری شده در بیمارستان است و در این بین رقم 14000مرگ هم به کودکان تعلق میگیرد.

2. التهاب روده
روده های ما دارای 100 تریلیون باکتری از گونه های مختلف است. در عین اینکه بعضی از آنها می توانند کشنده باشند، یک تعادل دقیق و طبیعی بین آنها برقرار است، حال آنتی بیوتیک ها به این تعادل ضربه می زنند. این باکتری های کارآمد، که به عنوان فلور روده شناخته می شوند، سیستم ایمنی و هاضمه را پشتیبانی میکنند. آنتی بیوتسک هایی که بیش از حد قوی هستند، در زمانی که شما واقعا عفونت دارید، مفیدند اما می توانند تعداد زیادی از باکتری های مفید روده را نیز از بین ببرند. بسیاری از افراد ازجمله کودکان در معرض عوارض جانبی نتی بیوتیک های اضافه قرار دارند از جمله کودکان.
این نوشته را هم بخوانید : فوم ویسکو الاستیک | مزایا، کاربردها و کالای خواب

3. مضر کردن باکتریهای مفید
آنتی بیوتیک ها موجب می شوند باکتری های مفید، مضر شوند باکتری ها مانند بقیه موجدات زنده نیازی به تولید مث برای انتقال ویژگی هایشان ندارند، باکتری ها می توانند به راحتی ویژگی های ژنتیکی را توسط عمل خاصی به نام ترانسفورماسیون انتقال. به همین دلی است که اگر آنها ژن های مقاومت نسبت به آنتی بیوتیک را به یکدیگرمنتقل کنند جمعیت باکتری های مقاوم بیشتر هم می شود.
4.افزایش ابتلا به بیماری سوزاک
آنتی بیوتیک ها موجب افزایش موارد ابتلا به سوزاک غیر قابل درمان شده اند در خصوص تحقیقات درباره سی دیف، نوع لا مقاوم بیماری سوزاک نیز دنبال شد. این نوع سوزاک لاعلاج، علاوه بر درد، مرتبط شده است با بیماری های دیگری چون التهاب لگنی، حاملگی خارج رحمی، نازایی و عفونت چشمی کودکان و…
5.مقاومت بدن در مقابل آنتیبیوتیک
آنتی بیوتیک ها خرج بیمارستان ها را زیاد کرده اند گسترش مقاومت آنتی بیوتیک موجب دشوار تر شدن درمان در بیمارستان ها شده است، زیرا در این شرایط باید از اشکال پرخرج تر و آنتی بیوتیک های نایاب تری استفاده کرد که خرج را هم برای بیمارستان هم برای بیمار افزایش می دهد.